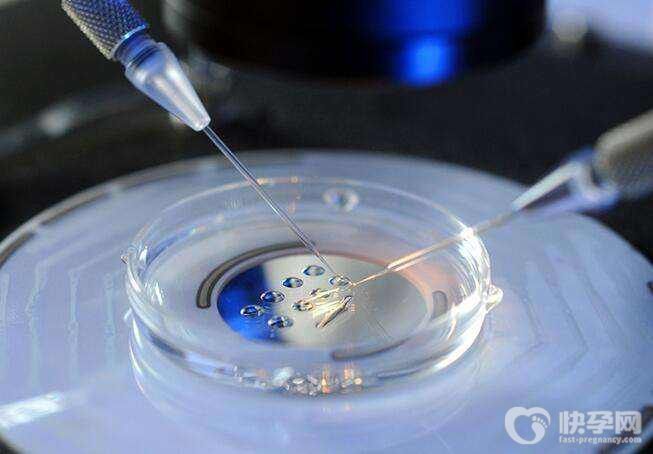

实述一位43岁患有卵巢早衰试管成功怀孕案例分析总结
- 试管成功案例
- 2025-01-20 11:08
我的大姑今年43岁,原本有三人之家的幸福家庭,天有不测风云,人有旦夕祸福。离当今已有五年了,那是一个夏天,天气比往常还要炎热,我大姑的儿子,也就是我堂哥,这一年他13岁,他跟村里的几个同龄的孩子一起约去游泳消暑。据说,当时我姑夫是没有在家里,在外面帮别人开车去了,没有提前经过大姑同时,我堂哥就跟他们一起在附近的大河里游泳,直接下午四点多左右,有两个孩子急急忙忙跑回来告诉大姑,说我堂哥在河里游泳不见人影了,这下我大姑感觉不好,立马丢掉手头的工作,直接跑向了河边,可怎么喊也没见有人回声,后面村里的会游泳的男汉子们,就真接跳到河里去寻找,一分钟、十分钟、半小时、一小时后,还是没有找到人。大伙说估计是被河里的淤泥给陷进去了,需要找专业打捞的人来进行打捞才行。在村里的男汉子在河里寻找时,我姑夫接到了通知,开着飞的赶回来了的,后面我姑夫通过关系找到了专业的打捞人员来打捞,同时,我大姑已经吓晕过去了,被送到镇上的卫生院了。经过长达三天两夜的打捞才找到遗体。这件事估计过了半年,我大姑和姑夫感觉太孤单了,想再生一个孩子,来弥补这种空虚感,听说他们备战了一年,没有动静,然后去医院做了相关的检查后,才知道具体为什么不能怀孕了,原来是我大姑患了卵巢早衰的原因,医生说,这种情况下,自然怀孕的机率很渺小,建议另求他法吧。
男性检查项目:抽血检查和精液检查两项,抽血检查主要为优生四项、肝功能、肾功能、血常规、血型、凝血四项、肝炎系列、染色体、梅毒、艾滋病、抗精子抗体等。精液检查主要为常规及畸形率、支原体衣原体等。
女性检查项目:抽血检查、白带检查和其它检查三项,抽血检查主要为优生四项、肝功能、肾功能、血常规、血型、凝血四项、肝炎系列、染色体、梅毒、艾滋病、抗精子抗体、抗子宫内膜抗体、甲状腺功能等。白带检查主要为白带常规、支原体衣原体检查、TCT等。其它检查包括排卵检测、心电图、乳腺彩超、肝胆脾彩超(空腹)、阴式B超、输卵管造影等。
审查资料
检查项目做完后,院方要求大姑他们提供身份证、结婚证、生育证,并且院方收走了这些资料的复印件。
促排卵
由于大姑患有卵巢早衰,但是还是有卵泡的,医生根据大姑的情况进行相关的方案,医生建议大姑他们先进行调养两到三个月后进再进行促排,同时还要服用相关的药物,到第三个月的月经期的3-5后来院服用捉排卵的药,还需要做卵泡监测等。
取卵环节
在第三个月里,我大姑取卵一次取了四颗,但医生建议现进行促排一次,最好是在8颗卵的情况下,做胚胎培育成功性会更大一些。
因此,将取了来的卵子需要进行冷冻,我大姑又经过了两个月的调养,在第二次的促排下,又取出了四个卵子,刚好凑齐了8颗卵子。同时,这次医生让姑夫取了精液。
胚胎培育
由于胚胎培育过程是由专业医师将卵子与精子进行人工培育,因此,大姑他们是不需要来医院的,直接等院方的通知就可以了。
胚胎移植
经过了五天的等待,大姑他们接到了院方的通知后,来到了医院进行移植,在移植前要求大姑先做了B超的检查,经检查后,发现由于取卵后,子宫内有点炎症,因此建议大姑先治疗并调养后再移植,需要进行了半个月的治疗和调养,其间由于不能马上移植,因此胚胎需要冷冻保存。另外,医生告诉他们,胚胎只有三个是合格的,经过半个月的治疗和调养后,大姑顺利的进行移植手术。再成功移植后,医院告诉他们一些关于移植后的相关注意事项,比如要卧床多久、什么时候可以洗澡,还有饮食方面的事项等等,要求十四天后来院确认着床情况。
确认妊娠
大姑他们在第十五天来的医院,经过抽血的检查后,医院告诉他们,已经成功着床了,但还是要多加注意,由于胚胎着床还没稳固,意外的风险还是蛮大的,建议他们密切注意观察。
三个月后
在大姑经过确认怀孕后,她几乎都没出过门,害怕不小心出现意外的情况,因此,是姑夫一直在忙前忙后的,终于在三个月后,肚里的宝宝稳定了,姑夫时不时的带大姑散散步,看他们脸上逐渐的恢复了往日的笑容,安心的等待新的生命到来。
卵巢早衰试管成功怀孕案例分析总结:
1、在孕期前孕期时都需要多吃些含蛋白质的食物补充营养,特别是卵巢功能不好的女性。如鸡、鸭、鱼、蛋、燕窝、虾、大豆及其制品都可以补充蛋白。
2、养成良好的生活习惯,早睡早起,千不要总是熬夜,真的很伤身体。
3、多做功课,多学习。经常看看其他患者的分享,看看其他人是如何成功的?学到了很多,例如促排前坚持榨豆浆喝,移植前经常泡脚。
4、保持乐观积极的心态,过程积极努力,结果交给老天。只要自己认真在做这件事,即便失败那也是老天爷另有安排。紧张、焦虑等不良情绪可能会影响到卵泡的发育,应激状态下的身体可能会分泌某些有害激素,进一步干扰身体的稳态。
5、医院一定要选择对,在做试管婴儿前要多方面进行打听,要选择有资质的三甲医院,收费明确、技术好、医生的临床经验足等。
 男性检查项目:抽血检查和精液检查两项,抽血检查主要为优生四项、肝功能、肾功能、血常规、血型、凝血四项、肝炎系列、染色体、梅毒、艾滋病、抗精子抗体等。精液检查主要为常规及畸形率、支原体衣原体等。
男性检查项目:抽血检查和精液检查两项,抽血检查主要为优生四项、肝功能、肾功能、血常规、血型、凝血四项、肝炎系列、染色体、梅毒、艾滋病、抗精子抗体等。精液检查主要为常规及畸形率、支原体衣原体等。

发表评论